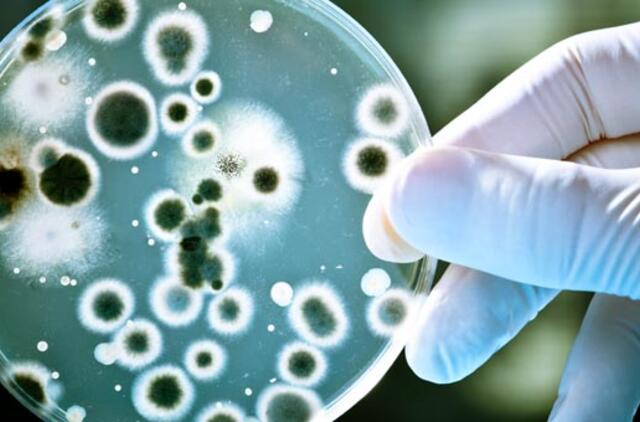
Amerikiečių medikai vėžį bandė gydyti, užkrėsdami pacientą bakterijomis

Dėmesio centre atsidūrė gydytojai Paulas Muizelaaras ir Rudolfas Schrotas. Jie trijų glioblastoma sergančių pacientų žaizdas užkrėtė bakterijomis Enterobacter aerogenes. Buvo manoma, kad pacientai mirs per artimiausias savaites. Infekcija gyvenimo jiems taip ir neprailgino. Beje, du iš jų mirė nuo sepsio.
Medikai manė, kad užkratas vers priešintis uždegimui, o tai paveiks ir navikus. Reikia pasakyti, kad ši idėja Kolumbijos universitete buvo tikrinama dar 2009 metais. Tada bandomuosiuose tyrimuose dalyvavo 382 žmonės, iškentę glioblastomos operaciją. Bandymų rezultatai neguodė – infekcija nuo vėžio neišgelbėjo.
Analogiškas tyrimas buvo atliktas ir Romos Katalikiškame universitete, tačiau jo rezultatai nebuvo statistiškai reikšmingi.

Rašyti komentarą